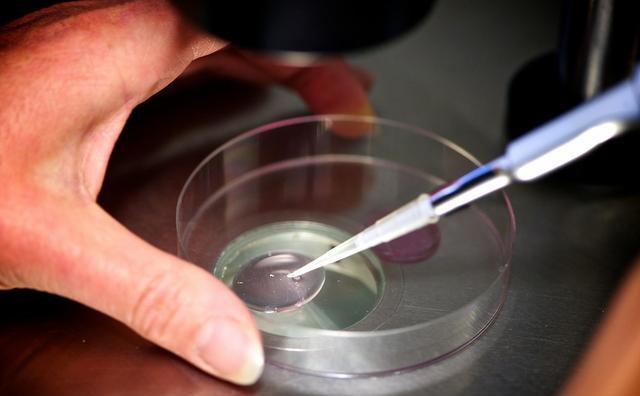
12d2a64d3d7f48279f74d2a847f523b87ea36c657b1d57e36c12d1bb95ff5dc91525312760925.jpg

做试管婴儿的姐妹们常常听到冻胚这样一个名词。什么是冻胚,我们在什么情况下需要考虑冻胚,什么时候安排冻胚移植合适呢?
冻胚即冷冻胚胎,是将通过试管婴儿培育技术得到的胚胎,存置于零下196℃的液氮环境中,从而得以长时间的保存,待以后的自然周期或人工周期进行胚胎复苏移植。

鲜胚和冻胚的区别和优劣
新鲜胚胎是在体外经过受精培育后,将胚胎直接移植到子宫腔内。
冷冻胚胎是在胚胎培养后,使用胚胎冷冻技术,将胚胎冷冻保存。在取卵周期后的某个月经周期内的特定时间点,将胚胎解冻复苏,然后移植入子宫腔的过程。
从胚胎角度来说,鲜胚移植减少了冷藏与解冻清醒的历程,成活性会更高,但在促排卵期间,母体需要接受注射促排卵药物,代谢掉这些药物需要一定的时间,在此期间子宫可能会受到药物的影响,所以新鲜周期移植对胚胎会有一定的影响。
冷冻胚胎解冻移植一般是在母体经过一段时间的休息后再植入,子宫便有足够的时间恢复到更加自然和健康的状态。另外,胚胎在冷冻和复苏过程,都可能造成胚胎超微结构或生物大分子的损坏,从而降低了胚胎的发育潜能,而其他存活下来的胚胎则说明更为强壮,成功率也会更高。
我们在什么情况下需要考虑冻胚呢?
冻胚的适用对象(适应症)为:
IVF(ICSI)治疗周期过程中胚胎移植后剩余可以利用的胚胎;
促排周期因母体环境不适合怀孕 (例如:发生严重卵巢过度刺激综合征、子宫内膜不佳或重度输卵管积水需要先行手术治疗等),也可先冷冻保存暂缓植入,待适当的时机再做解冻;
促排周期有发热、腹泻等全身性疾病不能移植的;
对于有可能丧失卵巢机能的病人(例如:要接受化学治疗、放射线治疗等),也可选择冷冻胚胎来保存其生育能力。
那么冷冻的胚胎在什么时候安排冻胚移植合适呢?
对于超促排卵周期如长方案或超长方案的建议在促排卵后的第三次月经来潮预约冻胚移植。
温和刺激促排卵周期的建议在促排卵后的第二次月经来潮预约冻胚移植。
微刺激或自然周期的建议在取卵后月经来潮即可预约冻胚移植。
如在促排卵治疗周期发生卵巢过度刺激综合征的建议在促排卵后的第三次月经来潮预约冻胚移植。
冻胚移植后未孕的月经来潮即可再次预约下一次冻胚移植。
前次胚胎移植妊娠后如发生胚停清宫的建议休息3个月以上再次预约冻胚移植。如果为生化妊娠可以根据周期类型不同按照前述1~5选择冻胚移植时间。如发生宫外孕行药物(MTX)保守治疗的建议休息6个月后再次预约冻胚移植,如为手术治疗在手术后休息一个月后即可再次预约冻胚移植。
冻胚移植几天能着床呢?
试管婴儿冻胚移植移植后着床通常需要3-5天才能着床。由于每个女性的身体条件等不相同,试管婴儿移植冻胚着床的时间也不同。有些女性在移植后3-7天冻胚就成功的着床,有些女性则需要7-14天才能够成功着床。所以医生通常建议通过试管婴儿助孕的女性朋友,在试管婴儿移植后的第14天来医院抽血检查冻胚是否着床、是否怀孕。
冻胚移植后注意事项:

第一,移植后不要憋尿,有尿意要及时解手。膀胱位于子宫的前面,当膀胱里面有很多尿液的时候就会压迫子宫,可能引起子宫的收缩;
移植后多喝水,多解手。因为移植手术不能使用消毒液,避免对胚胎的影响,医生做这些手术时只是充分冲洗阴道,而不是消毒。但女性的尿道很短,和阴道距离近,容易在手术操作后尿路感染。多喝水,多排尿就会冲洗尿道,减少尿路感染机会。
第二,移植后一般卧床休息2-3小时就可以了,年龄大也可以多躺一会。休息主要是为了让移植手术后子宫处于舒张的状态,全身放松有利于子宫的安静。
第三,移植手术后一段时间大家会比平时活动少一些,特别是取卵周期移植的姐妹,卵巢也比较大,不适合剧烈的运动,加上使用黄体酮的原因可能会出现肠道活动减少,大便干燥,便秘?;铺逋巳米庸簿?,对肠道的运动也会减弱。
这里有两点预防便秘的有效方法:
一是饭量要足够,肠道受到足够食物的压迫刺激,肠道的蠕动就会增加;
二是多吃一些富含纤维素的食物,如水果、蔬菜都会促进肠道的运动,这样就能避免便秘。
第四,提醒大家的是,在这两周期间,避免去人多,空气流通不好的地方;遇到天气变化,及时添加衣物,避免感冒。大家都知道感冒对怀孕是有影响的。
第五,按照医生叮嘱用药打针:移植后的两周一定要按照主治医生的叮嘱用药打针,因为用药要特别注意,按照医生的要求用药是怀孕的需要,打针也是为了更好的帮助胚胎着床。同时建议大家不要过早验孕,这样不但影响心情,而且还会影响成功率,就安安心心等到移植后14天到医院抽血验孕。
如果出现两条红线,一般就是怀孕了,要到医院在抽血化验雌孕激素,看是不是要加药;
如果只有一条线,还是请大家来医院再查血看看是不是怀孕,尿的检查有时候不一定准确。
所以,没有到较后一步,希望大家不要轻易放弃,也经常遇到有的病人自己检查只看到一条线,不来医院,就停药了,结果只能欲哭无泪了。